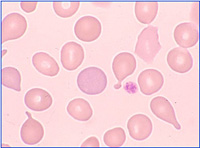

- 第2部 末梢血・骨髄像の見方&考え方
- 1. 三血球(系統)の分化・成熟 Point:細胞の成長期を正確にキャッチ!
- 三血球(系統)の分化・成熟過程 (白血球、赤血球、血小板系)
- 単球、リンパ球の分化・成熟過程
- 2. 実践的な観察 〜末梢血編〜 Point:対比細胞から標的細胞をスマッシュ!
- 血液細胞の基本構造と血球の大きさの相互関係
- 末梢血液像の着眼点:白血球系の見方
- 末梢血液像の着眼点:赤血球系の見方
- 末梢血液像の着眼点:血小板系の見方
- 3. 実践的な観察 〜骨髄編〜
Point:対比細胞から標的細胞をスマッシュ! - 骨髄像の着眼点:顆粒球系の見方
- 骨髄像の着眼点:赤芽球系の見方
- 骨髄像の着眼点:血小板系の見方
- 4. 大型細胞をいかに裁くか